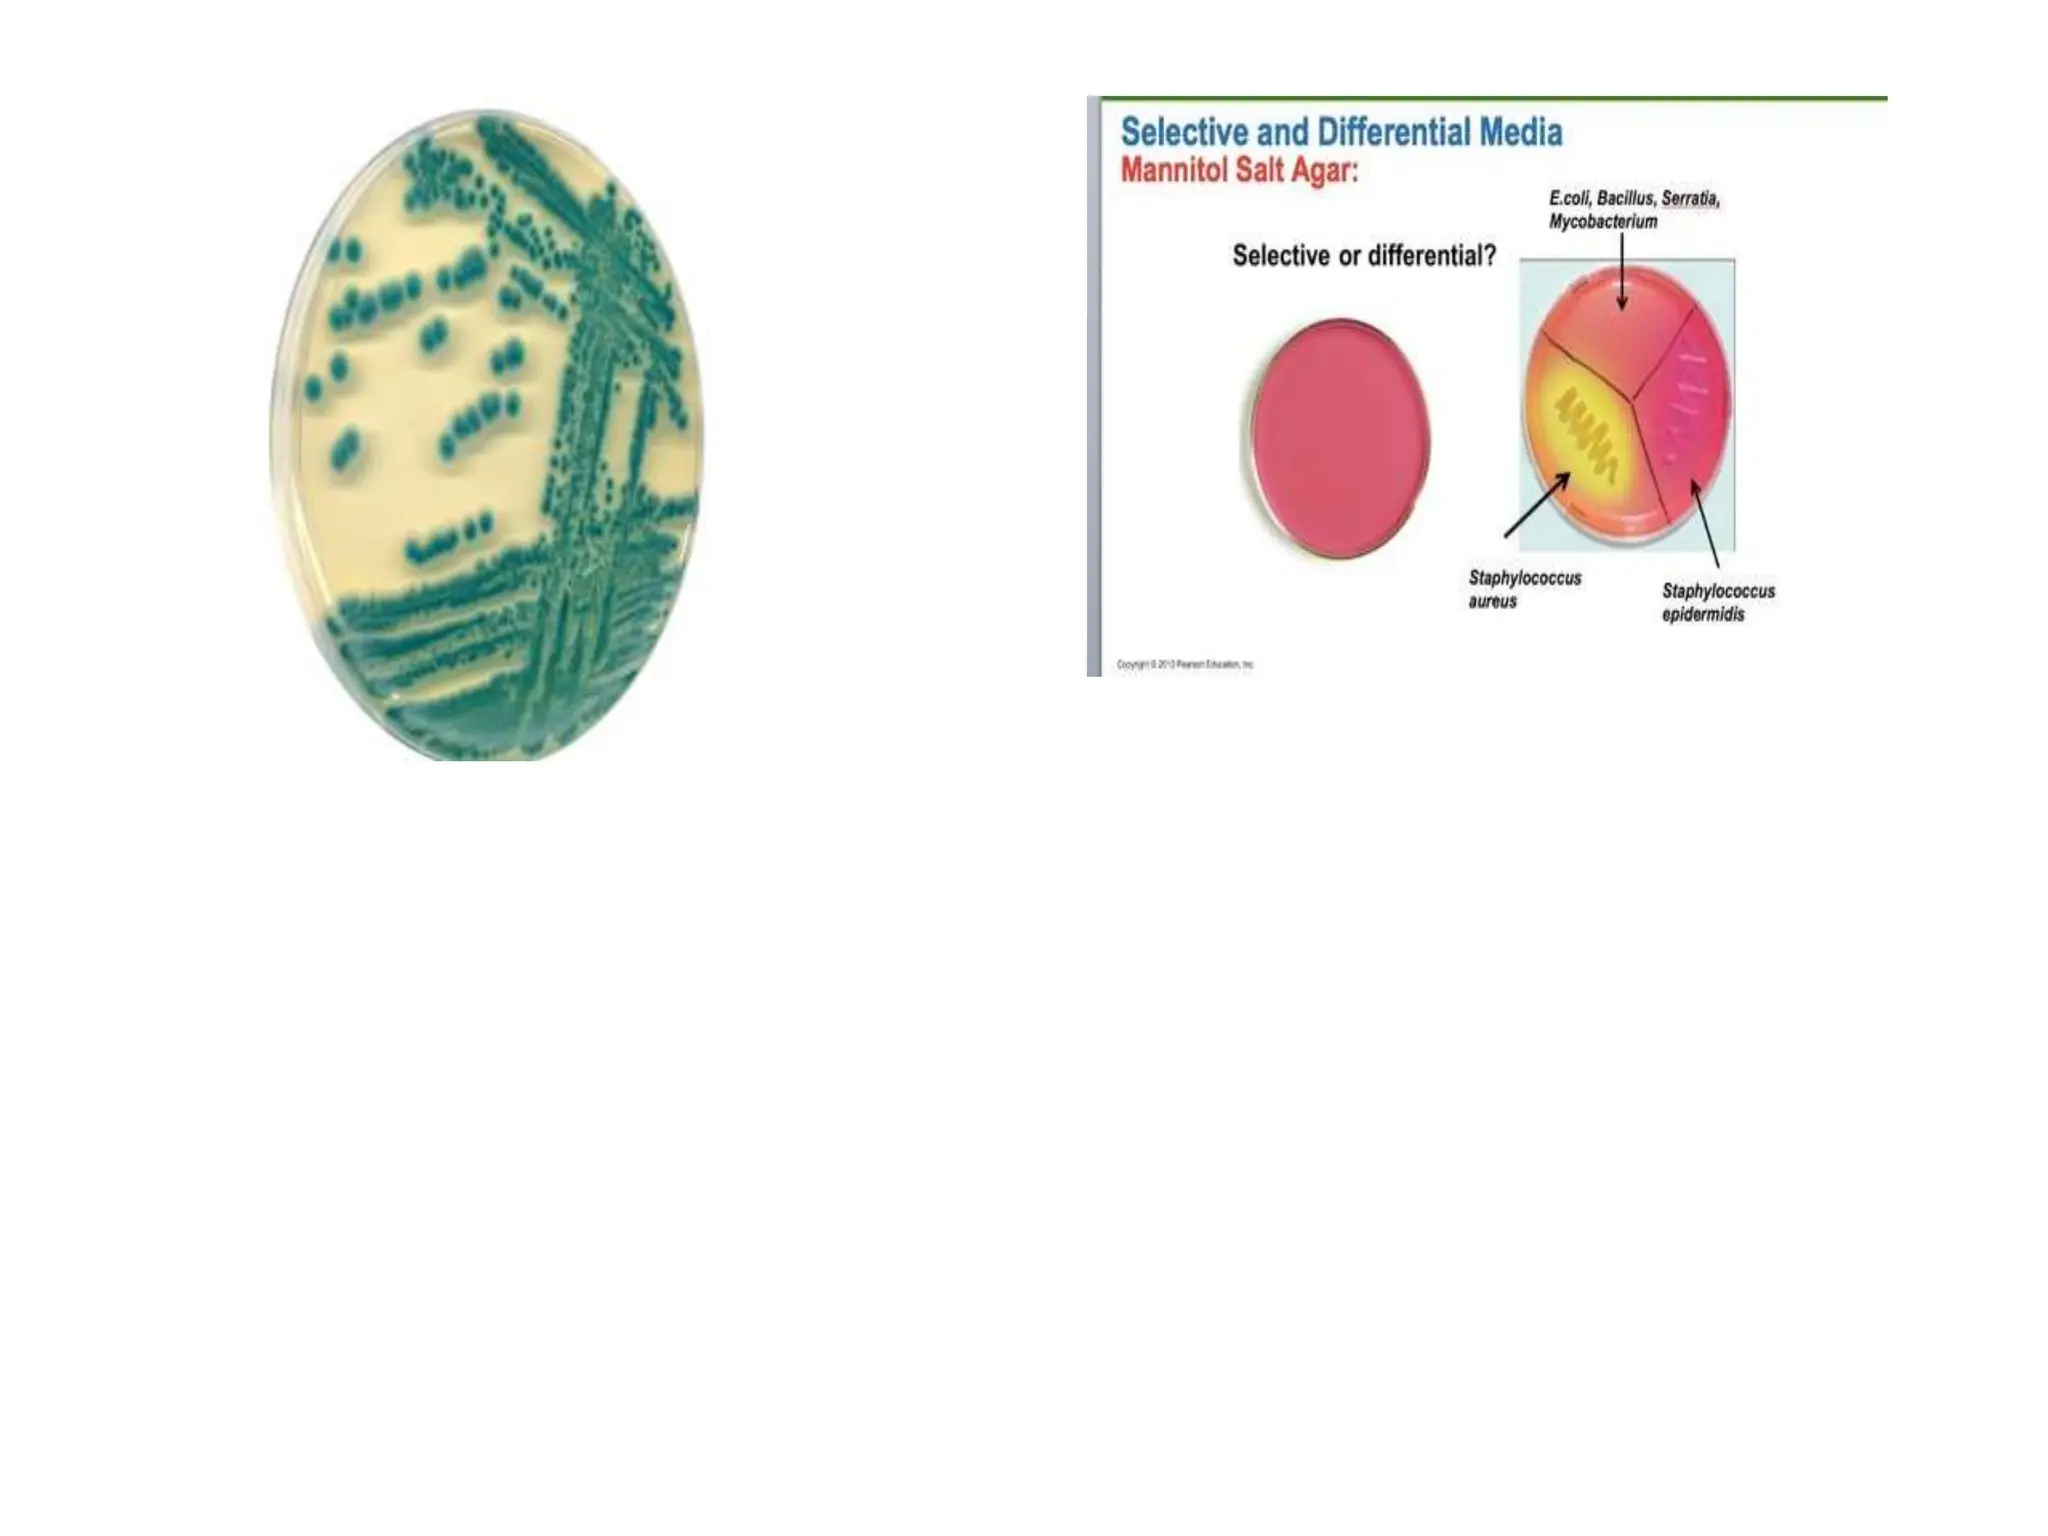

The document covers the study of microbiology, focusing on microorganisms, their classification, and key historical figures and their contributions, such as Pasteur and Koch. It outlines various fields within microbiology, including medical, pharmaceutical, and environmental microbiology, alongside classification criteria and methods for identifying bacteria. The text also explains microbial taxonomy, nomenclature, nutritional requirements, and the types of microscopes used in microbiological studies.

![Mechanisms of mutation
• a. Substitution of a nucleotide: Base
substitution, also called point mutation,
involves the changing of single base in the DNA
sequence. This mistake is copied during
replication to produce a permanent change. If
one purine [A or G] or pyrimidine [C or T] is
replaced by the other, the substitution is called
a transition. If a purine is replaced by a
pyrimidine or vice-versa, the substitution is
called a transversion. This is the most common
mechanism of mutation.](https://image.slidesharecdn.com/fms111ppt-240710130939-6a9ec5b5/75/Full-course-PPT-for-General-microbiology-301-2048.jpg)





















































































































